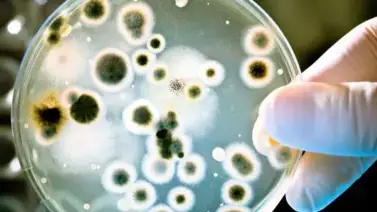
Ataca correctamente las bacterias y microbios conociendo sus diferencias Ataca correctamente las bacterias y microbios conociendo sus diferencias

Los términos "microbios" y "bacterias" a menudo se usan indistintamente, pero no son sinónimos. Ambos se relacionan con organismos microscópicos, pero abarcan conceptos diferentes. A continuación, se explican sus principales diferencias.
Microbios: un término amplio
Los microbios, también conocidos como microorganismos, son una categoría general que incluye a todos los organismos que solo pueden observarse con un microscopio debido a su diminuto tamaño. Este grupo abarca:
- Bacterias: organismos unicelulares procariontes.
- Virus: partículas infecciosas que no tienen células y necesitan invadir otras para replicarse.
- Hongos microscópicos: como levaduras y mohos.
- Protozoos: organismos unicelulares eucariotas que suelen vivir en ambientes acuáticos.
- Algas microscópicas: como el fitoplancton.
Incluso algunos organismos multicelulares extremadamente pequeños, como ciertos gusanos, a veces se incluyen bajo este término.
Bacterias: un subconjunto de los microbios
Las bacterias son un tipo específico de microbio y se caracterizan por ser organismos unicelulares procariontes, es decir, carecen de núcleo y organelos rodeados por membranas. Su material genético se encuentra en una región llamada nucleoide. Las bacterias se encuentran en casi todos los ambientes del planeta, desde el suelo hasta el interior del cuerpo humano, y cumplen funciones esenciales:
- Beneficiosas: como las bacterias intestinales que ayudan en la digestión.
- Patógenas: como las que causan infecciones como la neumonía o la tuberculosis.
Diferencias clave
1. Alcance: "Microbio" es un término inclusivo, mientras que "bacteria" designa un tipo específico de microbio.
2. Diversidad: Los microbios incluyen organismos celulares (como bacterias y hongos) y acelulares (como virus), mientras que las bacterias son exclusivamente unicelulares y procariontes.
3. Funciones: No todos los microbios son organismos vivos independientes. Por ejemplo, los virus no pueden reproducirse sin un huésped, a diferencia de las bacterias, que sí pueden hacerlo por sí solas.
En resumen, las bacterias son un subconjunto dentro del amplio mundo de los microbios, con características y roles específicos que las diferencian de otros microorganismos.
Visita nuestra sección Variedades
Mantente informado en nuestros canales
de WhatsApp, Telegram y YouTube